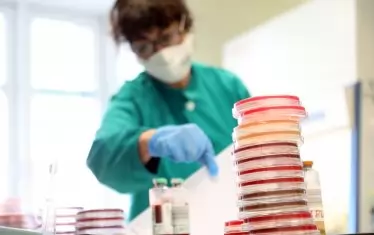
Лекарите отдавна са установили ползата от плацебото.

Изследванията едва ли изглеждат блестящ пример за лечебната сила на дадено лекарство. Пациенти с болки, депресия и дори с болестта на Паркинсон се лекуват със захарни хапчета, инжекции с физиологичен разтвор или дори с фалшиви операции. Страдащите от чрeвни проблеми са подлагани на неистинска акупунктура. На жени с поликистозни яйчници, които често са причина за безплодие, се предписват неистински лекарства. Тези "лечения“ не са най-нов вид медицински злоупотреби. А пациентите се чувстват по-добре, движат се по-добре, имат по-малко оплаквания, дори зачеват по-бързо.
Току-що влязохте в забавния свят на плацебото
Описаните измами всъщност са щателно проведени експерименти, чиято цел е да се изследва лечебната сила на ума. Смята се, че плацебото действа при произволно подбрани клинични изпитания – основен критерий, чрез който се търси научна обективност и се измерват резултатите. Плацебото обаче се превръща в изгряващата звезда в посветените на него изследвания, чиято цел е да се разбере силата на дозите и процедурите, които би трябвало да са напълно неефективни.
От десетилетия болногледачите дават в малки количества различни видове класическо плацебо – неактивно хапче, съдържащо захар или нишесте. Предлага се на пациенти, които отчаяно искат някакво лечение, но такова не е на разположение или няма необходимост от него. Днес плацебо могат да бъдат витамини, а не захарни хапчета, но целта е същата. Дори истинско лекарство може да бъде плацебо, ако се даде в минимална доза или при състояния, които няма вероятност да реагират на него. Тази практика се прилага много по-често, отколкото повечето пациенти могат да предположат: последно проучване сред американски интернисти и ревматолози показва, че около 50% от тях редовно предписват плацебо.
Плацебо се прилага масово, защото се оказва, че е „много по-мощно“, отколкото се смяташе преди, казва Фабрицио Бенедети от университета в италианския град Торино. Не само плацебото има истински ефект, а също така „напълно промени концепции и идеи“. Това повдига въпроси, свързани с психологията и физиологията, а изобщо да не говорим за предизвикателствата пред съвременните медицински практики.
Плацебото обичайно се определя по това, което няма: активни съставки. Не е правилно да се гледа на него по този начин.
„Плацебото не е пасивно вещество“,
пишат Бенедети и колегите му. „Съставено е от думи и ритуали, символи и значения, като всички тези елементи са активни при нагласата на мозъка на пациента“. Невронауката е нова, но познанието, че мозъкът може да заблуди тялото да се чувства по-добре, е използвано от лечителите в продължение на хилядолетия.
Промяната е, че в съвременния свят има нужда да сложим етикет на този процес, обяснява Джон Тилбърт от клиниката „Майо“. Лекарите са обучени да търсят обяснение причина-резултат. Те искат да могат да определят механизмите за подобрение, да видят „нещо“, а не „нищо“. Според Тилбърт, чиито проучвания са фокусирани върху взаимоотношенията и медицинските ценности, повечето пациенти „са прагматици, а не идеолози. Те искат да се почувстват по-добре и не се интересуват много как е постигнато това”. Плацебото е един от начините пациентите винаги да се почувстват по-добре. Наричайте го както си искате, „но определено не е нищо“, допълва Тилбърт.
Как работи плацебото?
Невролозите искат да разберат това. Ключът към разбирането на мистерията на плацебото е, че то има не само един ефект, а много, казва Бенедети, който е автор на книгата „Мозъкът на пациента“. И за да се разбере това, трябва първо да стане ясно какво не е плацебото. Има хора, чието състояние се подобрява от само себе си. Някои пък се оправят, защото първоначално са се почувствали по-зле, отколкото наистина са били. Понякога и пациенти, и лекари се заблуждават, че виждат подобрение, макар че такова няма. Това не е плацебо ефект. Истинският плацебо ефект е психобиологичен феномен в мозъка, който води до видими промени в тялото.
Помислете за влиянието, което оказват очакванията. Това, което ни се случва, в известна степен зависи от това, което очакваме да стане, съзнателно или не. „Очакванията ни помагат да разпознаваме и класифицираме различните видове стимули. Това е важно за оцеляването“, смята психологът Джейн Метрик от Центъра за изучаване на алкохолни и други зависимости към Университета „Браун“. Освен това имат и целебна стойност. Очакванията могат да активират същите неврохимични пътища, които ни карат да искаме храна, вода и секс. Те също така могат да задействат или да отблъснат от човешкото тяло хормоните на стреса. Накратко, очакванията създават истинска, психологическа промяна, обикновено със скоростта на мисълта. И няма никакво значение, че могат да бъдат активирани от захарно хапче. Когато плацебото действа, това не означава, че симптомите на пациента (независимо дали са болка, депресия или тревожност) не са истински. Просто неврохимичните промени, създадени от очакванията за облекчение, са съвсем като истински.
Успехът на плацебо ефекта понякога се дължи на факта, че хората са подлежащи на дресиране животни. Спомнете си урока по биология за руския физиолог Иван Павлов и как той кара кучета да слюноотделят при звука на звънеца, след като започнали да го свързват с времето за хранене. По отношение на ефекта на плацебото може да се окажем като тези впечатляващи кучета.
Инжектирайте на болен морфин в продължение на няколко дни, а след това сложете на пациента физиологичен разтвор - тялото му ще реагира все едно получава морфин. Дори имунната ни система е податлива на приспособяване. Изследванията показват, че плацебото може напълно да наподобява имунопотискащи лекарства, които намаляват възможността за отхвърляне на трансплантиран орган, но също така облекчават симптомите на настинка и алергични реакции по кожата. Този вид приспособяване най-често е подсъзнателно.
Колко дълго действа плацебото? Учените не могат да отговорят със сигурност, тъй като досега проучванията са проследявали само краткосрочни резултати. Не е ясно и защо някои хора изглеждат имунизирани към плацебо. Вероятно има много фактори, сред които и генетични, които участват. Няма прост начин, по който да се определи кой ще реагира и кой - не.